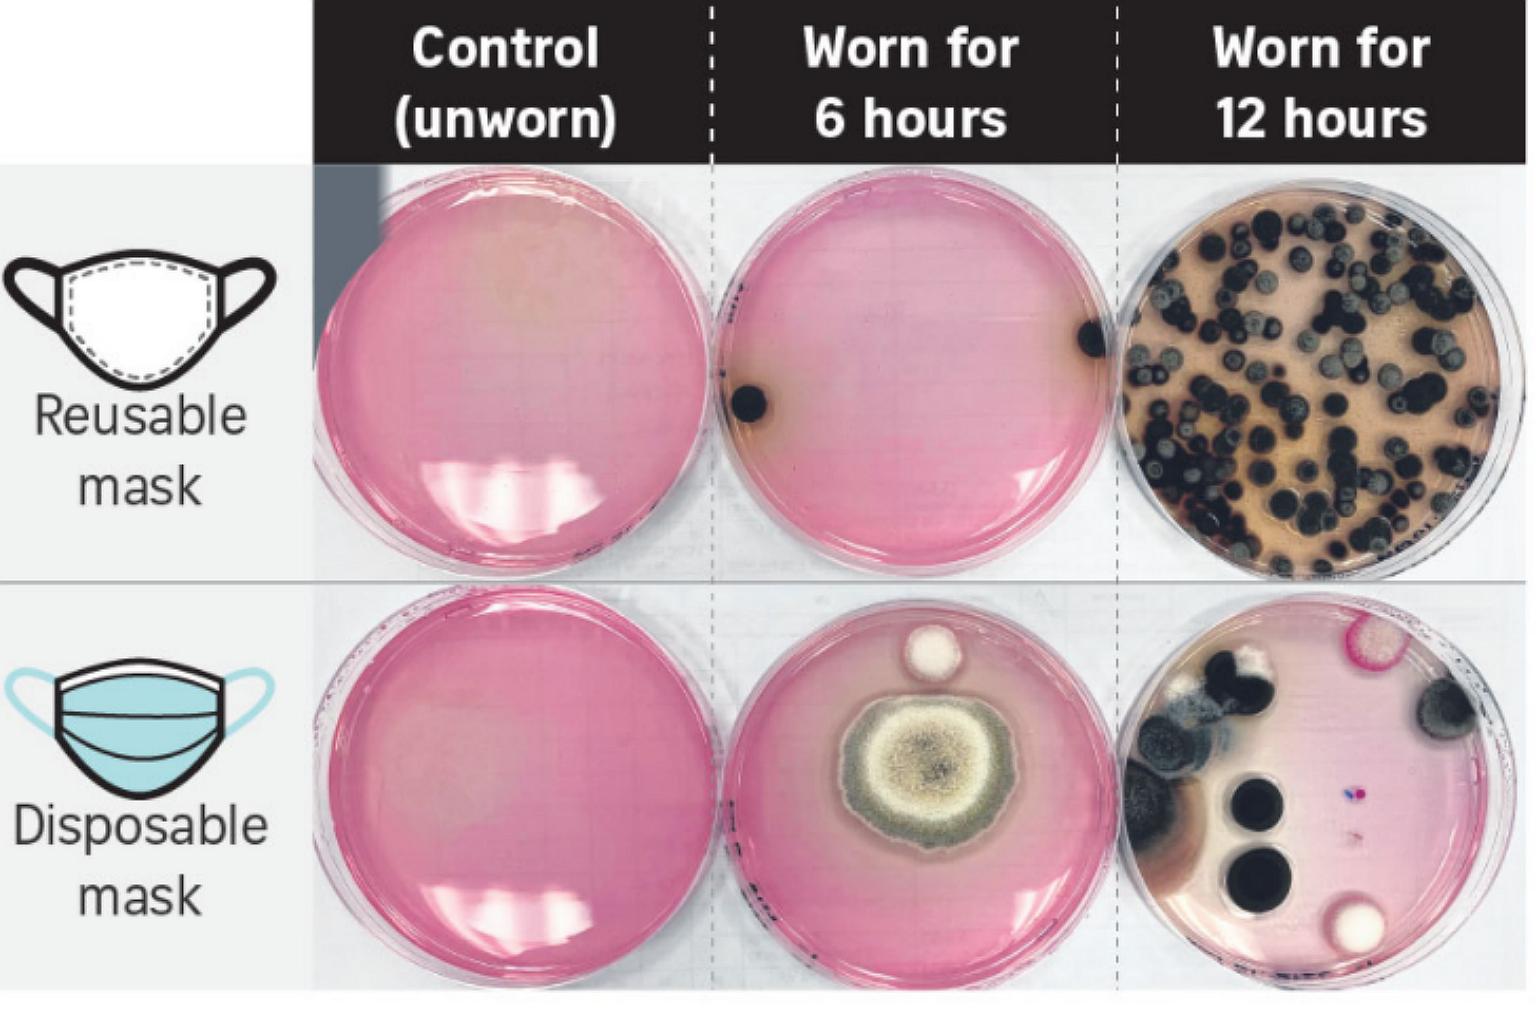

How often do you wash your mask? This is how a mask worn for 6 hours looks like
Sign up now: Get ST's newsletters delivered to your inbox
Microbiologists told The Straits Times that the warm and moist micro-environment within all masks tends to be conducive for microbes to thrive.
ST GRAPHIC
SINGAPORE - Masks that are worn repeatedly and for prolonged periods need to be washed often as they contain microbes from our skin and respiratory droplets, a study has noted.
An experiment by testing laboratory Eurofins showed that bacteria, yeast and mould were found in greater amounts when a mask had been worn for a longer period.
The experiment involved disposable and reusable masks that were worn for six hours and 12 hours for the purpose of comparison.
They were then tested for total bacterial count, yeast and mould, as well as Staphylococcus aureus, which is commonly linked to skin infections, and Pseudomonas aeruginosa, which is linked to rashes.
Though the S. aureus and P. aeruginosa strains were not present in any of the mask samples tested, levels of yeast and mould as well as the total bacterial counts were higher on the masks that had been worn for 12 hours.
The reusable masks generally contained more microbes than the disposable ones.
Microbiologists told The Straits Times that the warm and moist micro-environment within all masks tends to be conducive for microbes to thrive. But they noted that not all microbes are necessarily harmful.
Professor William Chen, director of Nanyang Technological University's Food Science and Technology programme, said: "Considering that we are surrounded by microbes in the environment and even within our digestive system (mouth and gut), it is not uncommon to find microbes on masks."
Further tests will have to be conducted to determine the kind of bacteria found on the masks and whether they could potentially cause diseases or skin conditions.
Dr John Common, principal investigator at the Skin Research Institute of Singapore, at the Agency for Science, Technology and Research, said S. aureus could produce a number of toxins that may sometimes be detrimental to human beings.
It is classified as a pathobiont, which means it could cause harm in certain conditions, although the bacterium can be commonly found in healthy people.
For instance, it is associated with atopic dermatitis, especially in people who may have a skin barrier that is more permeable, or have fewer natural defence mechanisms in their skin to reduce infections, said Dr Common.
He noted that P. aeruginosa could also colonise the skin, though it normally does so in wounded areas.
Dr Joel Lee, director at the School of Applied Science at Nanyang Polytechnic, said the material of the mask plays a part in entrapping bacteria after it has been used for 12 hours.
He noted that the key difference between disposable and reusable masks is the material of the inner layer that is closest to the mouth.
"This inner layer is most likely where bacteria can be coughed or sneezed onto, or they may be aerosolised into droplets when we talk into our masks," Dr Lee said.

Masks that are not washed frequently could trap dust, dirt, sweat and various other microbes.
PHOTO: ST FILE
He also noted that disposable masks offer better bacterial filtration and air permeability while reusable ones are made of a woven material that could result in larger spaces between fibres, thus offering poorer bacterial filtration.
ST also tested a reusable mask that had been worn for six hours in total and left unwashed for a week, and found remnants of bacteria, yeast and mould.
Masks that are not washed frequently could trap dust, dirt, sweat and various other microbes, said Dr Lee, adding: "This can trigger hypersensitivity, skin irritation or infection."
Dr John Chen, assistant professor at the department of microbiology and immunology at the National University of Singapore's Yong Loo Lin School of Medicine, said bacteria on masks are unlikely to result in something serious in the "vast majority of cases", but the presence of the occasional "opportunistic bacteria" may be a cause for concern.
Such bacteria, which reside on healthy skin, could grow to high levels on dirty masks and cause diseases. "At low levels, your immune system keeps them in check, but at high levels, they can cause mild to severe allergic reactions, respiratory problems, and even nasal infections," Dr Chen said.
As it is difficult to ascertain whether there may be harmful bacteria present on a mask, it is advisable for people to wash their masks frequently, or after each use where possible, he said.



